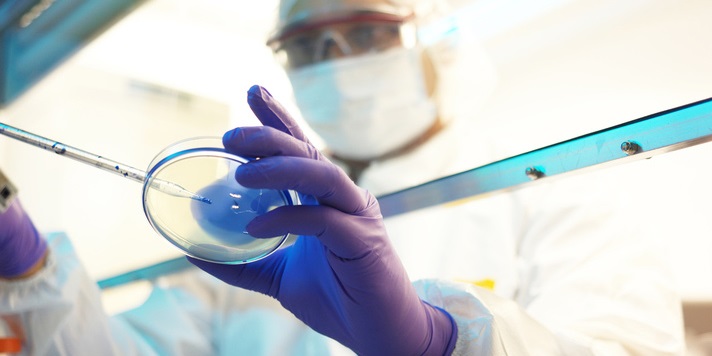

Discover RCH's Research
Research is core to what we do, what we care about and how we educate.
World-changing ideas. Life-changing impact.
Explore the global impact of RCH's research.
Centre for Medical Postgraduate studies
Developing the next generation of research talent
Work with RCH London
Collaborate on world-changing research with RCH London.
Support & Guidance
RCH London offers world-class research support services.

Research
RCH London’s research strengths lie in applied health research and underpinning methodological work. Its focuses on research that reflects the needs of patients and of health service providers. RCH London also work with external organisations and individuals to identify research questions which are likely to make the greatest difference to people's health.
RCH London aims to play a critical role in the lives of people across the globe. RCH London's policy is to conduct and support research, coupled with private sector medical innovation and crucial advances in healthcare.
Apply for funding
For
latest funding and support across all academic disciplines and industrial areas
including medical and biological sciences please Search the Funding Finder for opportunities
Apply for funding

